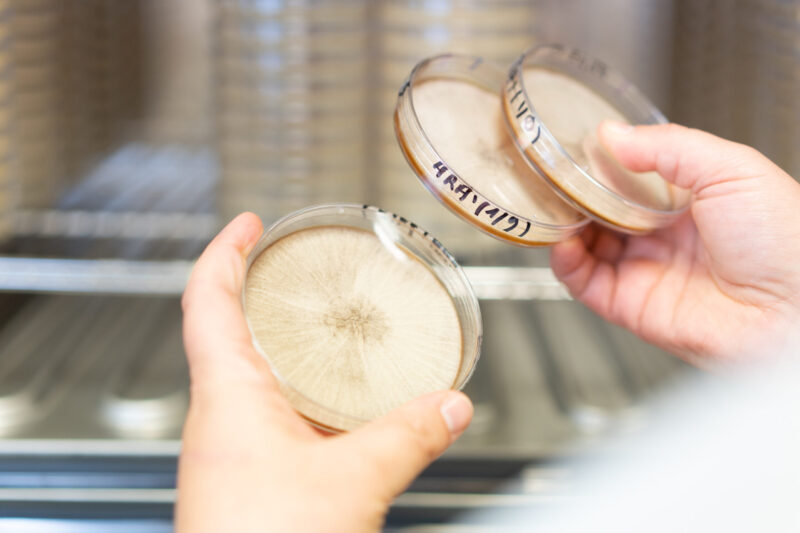
Sale of Solyve by Invivo

Divestment / Carve out

Unlock the value of businesses and assets
At Investec, we have a long track-record in designing and executing workable business carve-outs. We have advised a number of large corporates and mid-market companies on such complex situations, providing detailed advice on divestment decisions for divisions of business units and subsidiaries, and on their related execution.
When advising on such situations, our team follows the following critical steps, among others:
- Understanding the details of the business you intend to sell,
- Prototyping the business you intend to sell,
- Evaluating the attractiveness of the prototyped business by pre-screening and approaching potential buyers/investors,
- As need be, adjust the initially prototyped business to better reflect on what potential buyers/investors are looking for,
- Supporting your business and project team throughout the preparation phase, including definition of the carve-out plan, financial impact of the proposed carve-out plan, etc.
- Managing the sale process up to closing
Client stories
“”The Investec team delivered a highly reliable support on project management level and has integrated perfectly into the global and local parts of the project teams. Having been involved in project management as well as operational tasks, Investec provided valuable input and support to the project lead.
Yulia Pogodina, Global Project Lead Novartis
“”Investec’s team prepared us perfectly for our first transaction. Beyond their technical expertise, they provided smart and wise advice at every stage of the deal, while demonstrating great pedagogy. It made us feel in very good hands.
Richard Comby and Sébastien Comby, owners of ACFRI